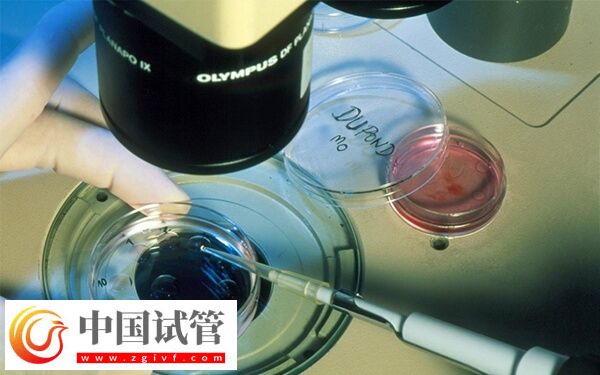
ivf和icsi的区别是什么(图2)

IVF(体外受精)和ICSI(单精子注射)是两种常见的辅助生殖技术,其中IVF(体外受精)是让卵子和精子是在体外培养皿中自然结合的,没有特殊干预,而ICSI(二代试管技术)则是将单个精子直接注射到卵子内部,以实现受精。此外,两者在适应人群、受精率等多个方面都存在一定的区别。

ivf和icsi的差异有哪些
试管婴儿技术中的ICSI和IVF是两种常见的方法,它们在受精过程上有所区别,并且各自适用于男性不育和女性不孕问题。如果大家想要确切的了解,两者之间的差异有哪些,如下所示:
1、适应症
ICSI和IVF是两种不同的辅助生殖技术,它们之间的主要区别在于受精过程。在IVF中,卵子与精子放置在培养皿中进行自然受精,而在ICSI中,则是通过显微操作将单个活跃精子直接注射到卵子内部。
2、适应人群
ICSI这种方法适用于男性存在少量或无法正常受精的情况。而IVF适用于女性因为输卵管阻塞、卵巢功能障碍或其他原因无法自然受孕的情况。
3、操作方法
ICSI通过显微操作,医生可以选择最优质的活跃精子注射到卵子内部,以增加受精的成功率。而在IVF过程中,医生会从女性身体中采集多个成熟卵子,并与精子一起放置在培养皿中进行自然受精。然后,选取最好的胚胎植入到女性子宫内,希望能够成功发育成婴儿。
4、成功率
无论是ICSI还是IVF,在成功率方面都有一定差异。具体来说:
- ICSI:对于男性不育问题,ICSI的成功率较高。根据统计数据显示,ICSI的受孕率通常在50%左右;
- IVF:对于女性不孕问题,IVF可以取得较好的成功率。根据统计数据显示,IVF的受孕率通常在40%至45%之间。
不过这些数据并非绝对准确,并且每个夫妇的情况各不相同。因此在选择适合自己的试管婴儿技术时,建议向专业医生咨询并根据自身情况做出决策。
ivf和icsi的优缺点
ICSI和IVF各有其优缺点:
首先来看ICSI,由于其直接将单个活跃精子注射到卵子内部,因此对男性不育问题有较好的治疗效果。同时ICSI也可以选择最优质的精子进行注射,提高了受精的成功率,然而ICSI并不能解决女性不孕问题。
而IVF则相对更适用于女性不孕问题,通过采集多个成熟卵子进行受精,提高了受孕的机会。同时IVF也可以通过胚胎质量评估,选择最好的胚胎进行植入,从而提高了成功率。然而IVF在处理男性不育问题上效果不如ICSI。
试管婴儿技术应该怎么选择
在选择ICSI和IVF之间,没有一个明确的答案可以说哪种方法更好。实际上在很多情况下医生可能会同时采用ICSI和IVF,以提高受孕的成功率。因此在选择试管婴儿技术时,应该根据个人情况来决定。
- 如果男性存在不育问题或者精子质量较差,那么ICSI可能是更好的选择;
- 而对于女性存在不孕问题的情况,则可以考虑使用IVF。





